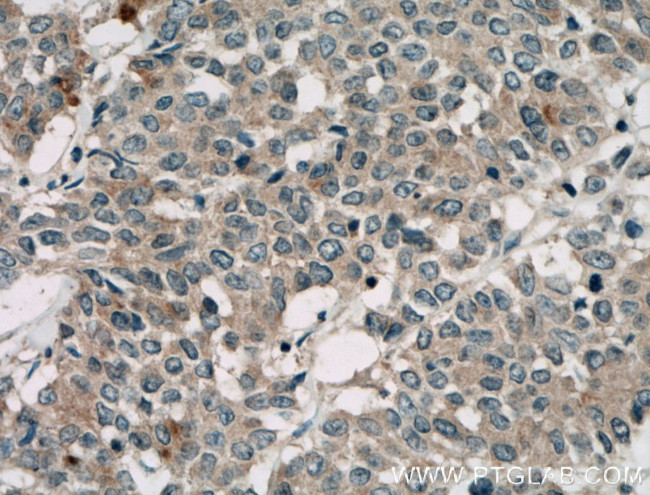
TAB1 Antibody in Immunohistochemistry (Paraffin) (IHC (P))

Search
Proteintech
TAB1 Polyclonal Antibody
{{$productOrderCtrl.translations['antibody.pdp.commerceCard.promotion.promotions']}}
{{$productOrderCtrl.translations['antibody.pdp.commerceCard.promotion.viewpromo']}}
{{$productOrderCtrl.translations['antibody.pdp.commerceCard.promotion.promocode']}}: {{promo.promoCode}} {{promo.promoTitle}} {{promo.promoDescription}}. {{$productOrderCtrl.translations['antibody.pdp.commerceCard.promotion.learnmore']}}
产品信息
27566-1-AP
种属反应
宿主/亚型
分类
类型
抗原
偶联物
形式
浓度
规格
纯化类型
保存液
内含物
保存条件
运输条件
产品详细信息
Immunogen sequence: TSKTSVTLS LVMPSQGQMV NGAHSASTLD EATPTLTNQS PTLTLQSTNT HTQSSSSSSD GGLFRSRPAH SLPPGEDGRV EPYVDFAEFY RLWSVDHGEQ SVVTAP (400-504 aa encoded by BC050554)
靶标信息
TGF-beta-activated kinase 1 and MAP3K7-binding protein 1 (TAB1) is a regulator of the MAP kinase kinase kinase MAP3K7/TAK1, which is known to mediate various intracellular signaling pathways, such as those induced by TGF beta, interleukin 1, and WNT-1. TAB1 interacts and thus activates TAK1 kinase. It has been shown that the C-terminal portion of TAB1 is sufficient for binding and activation of TAK1, while a portion of the N-terminus acts as a dominant-negative inhibitor of TGF beta, suggesting that this protein may function as a mediator between TGF beta receptors and TAK1. It can also interact with and activate the mitogen-activated protein kinase 14 (MAPK14/p38alpha), and thus represents an alternative activation pathway, in addition to the MAPKK pathways, which contributes to the biological responses of MAPK14 to various stimuli.
仅用于科研。不用于诊断过程。未经明确授权不得转售。
生物信息学
蛋白别名: beta activated kinase-1 binding protein-1; MGC57664; mitogen activated protein kinase kinase kinase 7 interacting protein 1; mitogen-activated protein kinase kinase kinase 7 interacting protein 1; Mitogen-activated protein kinase kinase kinase 7-interacting protein 1; RP3-407F17.2; TAB1beta; TAK1-binding protein 1; TGF-beta-activated kinase 1 and MAP3K7-binding protein 1; TGF-beta-activated kinase 1-binding protein 1; transforming growth factor beta-activated kinase-binding protein 1; unnamed protein product
基因别名: 2310012M03Rik; 3'-Tab1; b2b449Clo; MAP3K7IP1; TAB1
UniProt ID: (Human) Q15750, (Mouse) Q8CF89
Entrez Gene ID: (Human) 10454, (Mouse) 66513